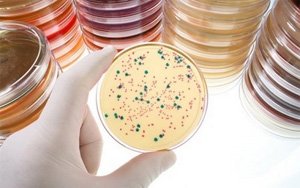
Диагностика заболеваний
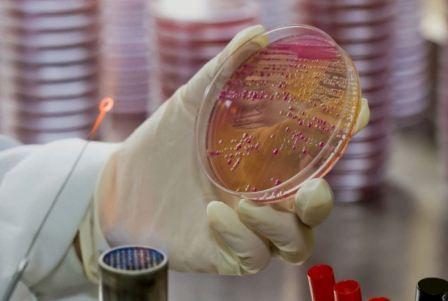
В кишечнике обнаружена клебсиелла, что это значит В кишечнике обнаружена клебсиелла, что это значит

В микрофлоре кишечника содержатся различные микроорганизмы, включая вредоносные бактерии. Среди которых присутствует и клебсиелла. Клебсиелла в кишечнике пагубно влияет на общее состояние здоровья человека. Терапия данного патологического состояния осуществляется длительно, поскольку клебсиелла обладает прочной оболочкой. Перед тем, как осуществить лечение рекомендовано проконсультироваться с врачом. Выбор метода терапии зависит от тяжести заболевания, индивидуальных и физиологических особенностей организма больного.
Особенности клебсиеллы в кишечнике
В чём опасность клебсиеллы? Клебсиелла устойчива к:
- ультрафиолетовым лучам;
- антисептическим средствам;
- некоторым антибиотикам.
По этой причине они остаются длительное время жизнеспособными. Только в процессе кипячения гибнут микроорганизмы. Безкислотная среда — является оптимальной для размножения данного анаэробного вида бактерий. Если в кишечнике присутствует небольшое количество клебсиелла, то проблем со здоровьем не возникнет. Когда их численность возрастает — развивается заболевание.
Чем опасна клебсиелла для человека?
Вследствие снижения защитных сил организма размножается клебсиелла. При таких условиях развивается:
- пневмония и другие патологии органов дыхания;
- заболевания мочеполовой системы;
- гастрит;
- энтероколит;
- энтерит;
- простатит;
- пиелонефрит.
Особенно опасно данное заболевание для:
- людей в возрасте;
- малышей;
- людей, у которых выявлены хронические болезни.
Клебсиелла в кишечнике у новорожденного
Чаще всего серьёзные заболевания у малышей развиваются вследствие внедрения в организм палочки фридлендера. Данный вид бактерий обитает в кишечнике, на слизистой оболочке органов дыхания и на кожном покрове. Палочка может нарушить функционирование внутренних органов малыша, поскольку иммунитет новорожденного только формируется. Если своевременно осуществить терапию, то можно предупредить развитие осложнений. В условиях стационара осуществляется терапия малыша в том случае, если патогенная микрофлора долгое время размножается в кишечнике, а иммунитет малыша ослаблен. При таких условиях часто диагностируются серьезные недуги, которые требуют своевременного лечения. Чаще всего клебсиеллу у грудничков диагностируют при:
- конъюнктивите;
- менингите;
- кишечных инфекциях;
- пневмонии;
- не проходящем насморке, гайморите.
Клебсиелла в кишечнике у взрослых
Значительно ухудшается самочувствие человека только в том случае, если увеличивается количество клебсиелла в кишечнике. Клебсиелла начинает размножаться при возникновении проблем с защитными свойствами организма. При таких условиях часто развивается воспалительный процесс или сепсис. Если не осуществить своевременное лечение, то возможен летальный исход. Микроорганизмы пагубно влияют на внутренние органы, суставы и слизистые оболочки. Бактерии можно встретить в грунте и воде.
Важно! Перед тем, как осуществить терапию рекомендовано обратиться за консультацией доктору, поскольку клебсиелла устойчива к многим сильнодействующим средствам. Самолечение может только спровоцировать развитие осложнений. В процессе возникновения заболевания поражаются органы ЖКТ и нарушается функционирование мочеполовой системы.
Основные причины возникновения болезни
Вследствие снижения защитных сил организма в кишечнике начинает размножаться клебсиелла. Существует несколько факторов, исходя из которых может произойти заражение:
- несоблюдение элементарных правил гигиены;
- нарушение технологии приготовления продуктов;
- часто поражение болезней происходит в медицинском учреждении (через руки человека, который контактировал с больным.
На заметку! Как показывает медицинская практика, чаще всего клебсиелла размножается вследствие нарушения норм гигиены — через грязные руки.
Симптоматика патологического состояния
Уже на начальном этапе развития заболевания присутствует симптоматика болезни. При поражении клебсиеллой начинают развиваться другие заболевания:
- энтероколит;
- энтерит;
- цистит.
К основным симптомам клебсиеллы относят:
- значительно возрастает температура тела;
- появляются болезненные ощущения в области живота;
- понос;
- слабость;
- в испражнениях присутствует кровь и слизистые выделения.
В процессе развития патологии нарушается работа легких, повышается температура тела. У больного возникает следующая симптоматика:
- боль в области грудной клетки;
- при кашле выделяется мокрота, которая включает в себя кровяные вкрапления;
- одышка.
Диагностические меры
В домашних условиях невозможно выявить наличие или отсутствие клебсиеллы. По этой причине рекомендовано посетить врача и пройти тщательный медицинский осмотр. На основе полученных данных, доктор определит индивидуальную схему терапии. Благодаря лабораторному исследованию можно выявить бактерии в мокроте, мочи, крови и кале. Процесс диагностики включает в себя:
- сдачу общего анализа крови;
- анализ мочи;
- сдачу анализа мокроты;
- анализ кала.
Клебсиелла пневмония
Клебсиелла в испражнениях 100/ 1 грамм — это нормальный показатель количества микроорганизмов. Если данная цифра значительно выше, то осуществляется немедленная терапия заболевания. Если не начать своевременное лечение, то возникнут инфекционные и трудноизлечимые болезни. Клебсиелла пневмония и клебсиелла окситока — самые опасные микроорганизмы для человека. Первые энтеробактерии устойчивые к высокой температуре и сильнодействующим препаратам. По этой причине терапия осуществляется долго.
Клебсиелла окситока
Не во всех случаях присутствие данной бактерии в организме человека свидетельствует о том, что развивается заболевание. Клебсиелла окситока присутствует на кожном покрове, в моче и органах ЖКТ, что считается нормальным явлением. Если инфекция активизируется, то развиваются патологии. При появлении следующих симптомов необходимо обратиться к врачу:
- Повысилась температура тела.
- Возникли колики в области живота.
- Присутствует длительное время диарея и метеоризм.
Читайте также:
К чему может привести пневмония
Лечение клебсиеллы в кишечнике
В частных случаях лечение такого патологического состояния осуществляется в условиях стационара. Терапия должна быть комплексной, поскольку есть вероятность смерти пациента. В первую очередь необходимо устранить признаки интоксикации. Врач назначает больному антимикробное лекарство, которое поможет улучшить самочувствие больного. Кроме этого, выписывает:
- антибиотики;
- ферментные средства;
- витаминные комплексы;
- пробиотики и бактериофаги.
Дозировку подсчитывает доктор, в зависимости от конкретной клинической картины пациента.
Прием бактериофагов
Благодаря очищенным бактериофагам можно побороть клебсиеллу. В процессе лечения данным лекарственным средством не возникает аллергическая реакция, противопоказания отсутствуют. После приёма препарата угнетается действие патогенной палочки. В нее попадает компоненты, которые разрушают бациллу изнутри. Выпускают бактериофаги в виде аппликаций, спреев и растворов. Длительность терапии определяет доктор, в зависимости от силы проявления заболевания.
Применение антибиотиков
В процессе терапии клебсиеллы врач назначает антибиотик. Перед тем, как осуществить терапию необходимо сдать лабораторные анализы — они помогут определить вид возбудителя и восприимчивость бактерий к медикаментам. Лечение клебсиеллы осуществляется при помощи:
- «Гентамицина»;
- «Цефтриаксона»;
- «Тобрамицина».
Пробиотические средства
Врач назначает пробиотики и бактериофаги в том случае, если инфекцией поражён кишечник. Кроме того, следует принимать бифидо — и лактобактерии. Они пагубно влияют на патогенные палочки и помогут восстановить микрофлору кишечника. Длительность терапии 7-9 суток. Среди самых эффективных пробиотиков выделяют:
- «Бифидум»;
- «Линекс»;
- «Аципол»
- «Бифиформ».
Дозировка определяется индивидуально. Ели осуществить грамотную терапию, то можно снизить риск развития осложнений.
Важно! В процессе лечения нужно не только принимать лекарственные препараты, которые назначил врач, но и правильно и сбалансированно питаться. Это поможет укрепить организм.
Лечение народным средством
Перед тем, как осуществить лечение народным средством рекомендовано проконсультироваться с врачом, поскольку самолечение может навредить. Одного народного средства недостаточно для того, чтобы побороть недуг. Терапия такого патологического состояния должна быть комплексной. В процессе лечения важно включить в рацион яблоки и клюкву, пить травяные отвары — это повысит иммунитет.
Лучшее средство
Березовые почки (200 г) необходимо залить кипятком (1 ст.). Отправить настаиваться в течение 3 часов. Перед применением процедить и пить на протяжении дня. Сухую ромашку (3 ст. л.) залить кипятком (1 ст.). Отправить настаиваться в течение часа. Растение обладает антисептическим действием. При таких условиях улучшается самочувствие больного. Целебный напиток лучше пить на голодный желудок. Если в процессе лечения значительно ухудшилось самочувствие, то необходимо обратиться к врачу и сообщить ему всех неприятных симптомах, которые доставили дискомфорт.
Клебсиелла – это грамотрицательный микроб из семейства энтеробактерий. Является представителем нормальной микрофлоры кишечника. Способен вызывать клинические проявления болезни, только при большом количестве клеток. У взрослых развиваются типичные поражения пищеварительного канала, у детей первого года жизни не исключается тяжелое септическое состояние.
Чем опасен возбудитель?
Содержание клебсиеллы в пределах нормы не представляет какой-либо угрозы для человека любого возраста. Опасность для организма взрослого и ребенка представляет не столько сам возбудитель, сколько его количество.
Значительное обсеменение пищеварительного канала человека приводит к:
- развитию диарейного синдрома;
- тяжелой общей интоксикации;
- выраженному обезвоживанию;
- серьезному нарушению микробиоценоза кишечника (дисбактериоз);
- в крайне тяжелых ситуациях – к общему заражению крови (грамотрицательный сепсис).
Клебсиелла у новорожденных (грудничков или детей первого года жизни) вызывает такие же изменения, как и во взрослом организме, но вылечить их значительно сложнее. Изменения водно-электролитного баланса и другие метаболические процессы у малышей меняются очень быстро (буквально в течение нескольких часов), а скорректировать их сложно.
Пути передачи и рост бактерий
По микробиологической классификации, выделяют такие варианты клебсиеллы:
- variicola;
- steroids;
- senegalensis;
- quasipneumoniae; (подвиды similipneumoniae и quasipneumoniae);
- pneumoniae (подвиды rhinoscleromatis, ozaenae);
- michiganensis;
- granulomatis;
- oxytoca;
- milletis.
В человеческом теле (на поверхности кожи и слизистых, внутри половых путей, внутри пищеварительного канала) обнаруживаются практически все вышеперечисленные варианты. В каловых массах определяют только 3 вида клебсиеллы: pneumoniae, aerogenes, oxytoca. Их количество не должно превышать 1000 в 1 грамме фекалий.
Клебсиелла передается практически всеми путями, известными эпидемиологии:
- пищевым (через загрязненные продукты);
- контактно-бытовым (при использовании грязных предметов общего пользования – посуда, игрушки, полотенца);
- водным (при употреблении некипяченой воды).
Читайте также:
Растирание при пневмонии у детей
Источником инфекции является только человек – больной с явными клиническими проявлениями или здоровый носитель. Именно клебсиеллезная инфекция часто развивается как внутрибольничная, что чревато тяжелыми клиническими проявлениями и сложностями с терапией (формирование антибиотикоустойчивости).
Росту клебсиеллы способствуют неспецифические факторы:
- неправильное питание;
- повторяющиеся эпизоды инфекций другой этиологии;
- хроническая патология пищеварительного канала;
- длительное эмоциональное и физическое напряжение.
Соответственно, человек, который придерживается принципов здорового образа жизни, может не опасаться патологического роста клебсиеллы в кишечнике.
Симптомы клебсиеллезной инфекции
У взрослого
Протекает в виде классической кишечной инфекции. Отличительных признаков не имеет. Симптомы отличаются в зависимости от локализации патологического процесса.
При клебсиеллезном гастрите пациент отмечает:
- тошноту и рвоту;
- различной интенсивности боли в эпигастральной зоне;
- снижение аппетита;
- изжогу;
- диарея и вздутие живота, как правило, отсутствуют.
При клебсиеллезном энтерите (поражении тонкой кишки) человек отмечает:
- боли в животе разлитого характера;
- тошноту и повторные эпизоды рвоты;
- урчание, вздутие живота, отхождение большого количества газов;
- диарею без патологических примесей (кровь, слизь, гной);
- каловые массы обильные, с неприятным зловонным запахом.
При клебсиеллезном колите наблюдаются:
- боли умеренной интенсивности в нижних отделах живота;
- частые позывы на дефекацию и скудный стул;
- патологические примеси в фекалиях.
Вышеописанная клиническая симптоматика наблюдается при многих других случаях инфекционной и неинфекционной патологии, поэтому самостоятельно поставить диагноз клебсиеллезной инфекции невозможно.
У грудничка
Кишечная инфекция клебсиеллезной этиологии у грудничка по клиническим признакам не отличается от таковых у взрослых. Родителям ребенка следует обратить внимание на такие признаки:
- отказ от еды либо сосание груди вялое;
- продолжительный плач без видимой причины;
- беспокойство, в том числе и интенсивные движения ножками;
- в тяжелых случаях беспокойство сменяется вялостью и продолжительным сном (выраженная интоксикация).
Лечением кишечной инфекции у маленького ребенка должен заниматься только специалист и только в условиях стационара. У малыша высока вероятность развития осложнений, а состояние быстро может стать неконтролируемым с необратимыми последствиями.
Методы диагностики клебсиеллы
Для комплексной диагностики клебсиеллезной инфекции у детей и взрослых используются:
- общеклинический анализ крови (отмечается лейкоцитоз и сдвиг формулы влево);
- биохимический анализ крови (изменение концентрации и соотношения калия, натрия и других электролитов);
- копрограмма (покажет нарушение процессов всасывания и переваривания – наличие слизи, примесей жира);
- бактериологический посев каловых масс с определением количества клеток клебсиелл в 1 грамме фекалий.
Любой результат исследования не является самостоятельным диагнозом. Оценить все лабораторные тесты и сделать заключение о необходимости лечения может только врач (инфекционист, педиатр или семейный доктор).
Общие принципы лечения
Лечение необходимо только в случае клинических проявлений кишечной клебсиеллезной инфекции и изменении общего состояния. Обнаружение клебсиеллы в каловых массах или других биологических жидкостях человека поводом для терапии не является.
Для устранения клебсиеллезной инфекции используется диетическое питание, медикаменты различного действия.
Питание
В первые дни болезни больному назначается лечебный стол №1, ограничивающий механические и химические раздражители для пищеварительного канала. Разрешено:
- овсяная, манная, рисовая каши на воде;
- овощные супы без зажарки;
- паровые котлеты или тефтели;
- протертые и вареные овощи.
По мере улучшения общего состояния диетическое питание расширяется и возвращается к привычному питанию.
Препараты
Доктор может назначить такие препараты:
- кишечные антисептики для устранения клебсиеллы;
- антибиотики широкого спектра воздействия в тяжелых случаях;
- энтеросорбенты;
- пищеварительные ферменты;
- растворы для внутривенного введения для устранения интоксикации и обезвоживания.
Длительность терапии и ее составляющие определяются в индивидуальном порядке.
Прогноз и профилактика
Прогноз при своевременном обращении и вовремя начатом лечении благоприятный. Для профилактики клебсиеллезной инфекции необходимо:
- соблюдать правила личной гигиены;
- правильно питаться;
- следить за состоянием иммунной системы.
При любых сомнениях лучше обратиться к врачу, а не заниматься самолечением.
Такое заболевание, как клебсиелла в кишечнике, не все врачи считают опасным. Клебсиелла (klebsiella) — одна из наиболее часто встречающихся патогенных бактерий в кишечнике, которую легко обнаружить при исследовании микрофлоры каловых масс по методике Хомпса.
Что такое клебсиелла
Клебсиеллы разных видов встречаются повсюду и могут быть найдены и в продуктах, и в воде.
Медики до конца не выяснили способность этой бактерии, как, впрочем, и многих других условно-патогенных микроорганизмов кишечника провоцировать острые и хронические формы заболевания.
Поэтому обнаружение клебсиеллы в кишечнике не является каким-то значимым диагностическим критерием.
По версии FDA
Согласно отчетам FDA (Федеральное Агентство по надзору за качеством фармацевтических препаратов):
«В отношении продуктов питания Kлебсиелла пневмонии (klebsiell pneumoniae — отдельный род клебсиеллы) считается кишечным патогеном, поскольку она способна вырабатывать два вида энтеротоксинов (термостабильный и термолабильный).
Читайте также:
Остаются ли рубцы от пневмонии
Болезни, вызванные содержанием этих бактерий в пище, как правило, связаны с большим количеством возбудителя. В некоторых случаях колонизация желудочно-кишечного тракта клебсиеллой служит фоном для присоединения вторичной инфекции.
Кроме этого, клебсиеллы могут встречаться в непастеризованном молоке».
Таким образом, клебсиелла не считается слишком большой проблемой и не требует лечения.
По версии Википедии
Но если обратится к материалам Википедии, то прочитаем, что:
«Бактерия Клебсиелла — частая причина нозокомиальных инфекций дыхательных путей и мочевыводящих путей.
В организме человека бактерия клебсиелла может стать условием широкого спектра болезней, в частности, пневмонии, проблем мочеполовой системы, сепсиса, менингита, диареи и инфекционного поражения мягких тканей.
Некоторые виды клебсиеллы присутствуют в патогенезе болезни Бехтерева и других спондилоартропатий. Большинство этих патологических состояний у человека вызывает Kлебсиелла пневмонии; реже Клебсиелла окситока.
Особенно часто клебсиелла поражает детей, пожилых людей и пациентов с иммунодефицитом на фоне сопутствующих заболеваний (например, рака, ВИЧ-инфекции и др.).
В большинстве случаев причиной размножения энтеробактерии становится недостаточная обработка медицинского оборудования.»
По версии микробиологов
Если копнуть еще глубже, то можно найти информацию, представленную опытными экспертами в области микробиологии и экологии.
Например, доктор Алекс Васкес, авторитетный и уважаемый специалистом, считает:
«Во многих случаях колонизации пищеварительного тракта Kлебсиеллой человек не ощущает типичных желудочно-кишечных симптомов, таких как тошнота, рвота, запор или диарея. Пациенты жалуются на слабость и нарушение деятельности мозга (помутнение сознания).
Клебсиелла в кишечнике способна спровоцировать появление диареи и острого гастроэнтерита.
Эта инфекция влияет на развитие реактивных артритов, таких как анкилозирующий спондилит и др.
Поскольку это грамм — отрицательный микроорганизм, он продуцирует эндотоксин, который повреждает цитохром Р-450 и снижает клиренс и экскрецию лекарственных препаратов».
Затем доктор продолжает:
«У пациентов с острым и хроническим риносинуситом при определении микрофлоры выявляется разнообразное сочетание бактерий и грибков.
Что касается бактерий, то встречаются как анаэробные, так и аэробные виды. Среди грамм — положительных особенно часто определяются золотистый стафилококк и стрептококк, среди грамм — отрицательных микробов распространены клебсиелла пневмонии, протей мирабилис, бактероиды, гемофильная палочка и пептострептококки.»
Симптомы наличия клебсиеллы в кишечнике
Если собрать все вышеперечисленное, то получается, что кишечная клебсиелла может вызвать:
- Слабость, усталость,
- Помутнение сознания,
- Тошноту, рвоту, запор, диарею,
- Симптоматику интоксикации организма,
- Сепсис, менингит, воспаление мягких тканей,
- Анкилозирующий спондилоартрит,
- Воспалительные процессы урогенитального тракта (частые позывы к мочеиспусканию, дискомфорт при мочеиспускании, простатит у мужчин, вагинит у женщин и др.),
- Признаки поражения дыхательных путей, например, ринит (заложенность носа и насморк и др.).
Отчего же такое разнообразие признаков?
Путаница происходит из-за того, что у одного человека бактерия вызывает одни проявления, а у другого — совершенно иные.
Как влияет клебсиелла на организм
Многие факторы влияют на протекание патологического процесса. Например, если у пациента ослаблен иммунитет, нарушен нормальный режим питания, есть воспалительные заболевания органов и систем и низкий жизненный тонус, то в этих случаях клебсиелла создаст дополнительные проблемы со здоровьем.
Это важно учитывать, ведь в здоровом организме практически не развиваются хронические инфекционные процессы.
Упадок жизненных сил открывает ворота для вирусов и микробов, которые заполняют кишечник пациента, мочевыводящие пути, носовую полость и т. д.
Истощение жизненного потенциала во многом зависит от образа жизни людей:
- Большое количество вредных продуктов.
- Недостаток питательных веществ.
- Небольшое количество качественной пищи.
- Чрезмерная или недостаточная физическая активность.
- Нарушение режима сна и отдыха.
- Психоэмоциональные перегрузки и стрессы.
Таким образом, обнаружение этого микроорганизма в результатах анализа кала дает человеку повод задуматься о состоянии своего здоровья и улучшить качество жизни и пройти соответствующее лечение.
Intoxic — антигельминтное средство, которое безопасно выводит паразитов из организма.
Intoxic лучше антибиотиков, потому что:
1. В короткий срок убивает паразитов и мягко выводит их из организма.
2. Не вызывает побочных эффектов, восстанавливает органы и надежно защищает организм.
3. Имеет ряд врачебных рекомендаций, как безопасное средство.
4. Имеет полностью натуральный состав.
Подводя итоги
Клебсиелла — условно-патогенная бактерия, которая способна спровоцировать ряд патологических процессов в человеческом организме.
К сожалению, медицинская система не придает должного значения проявлению хронических симптомов.
Клебсиелла может вызвать серьезные проблемы только в некоторых ситуациях. Как и ряд других микроорганизмов, описанных в методике Хомпса, эта бактерия приводит к появлению болезни только на фоне снижения иммунного статуса.